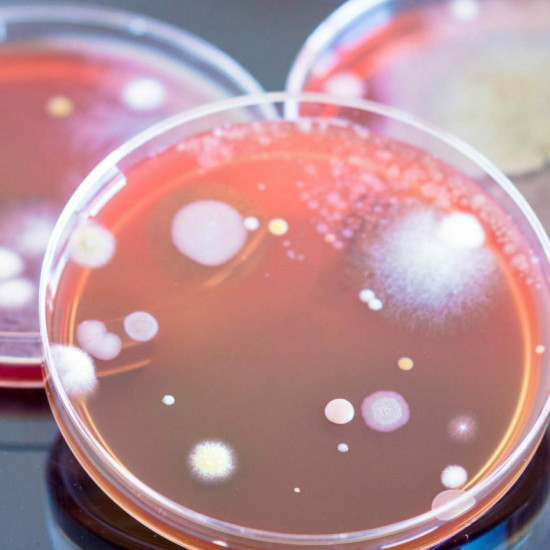

BioGenerator has been integral to the success of Omniose (formerly known as VaxNewMo). BioGenerator was the first organization to encourage and assist with our SBIR/STTR grant applications, helping Omniose secure more than $8M in NIH funding. BioGenerator also made the first equity-based investment in the company and helped us recruit an experienced leadership team to catalyze growth.
Christian Harding
Co-Founder and CSO, Omniose
